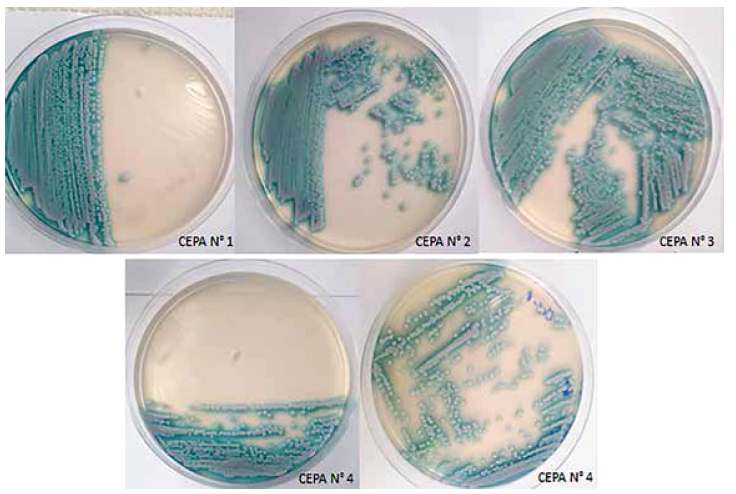

INTRODUCCIÓN
Candida auris es un microorganismo emergente, reportado por primera vez en Japón el año 2009 en una paciente a partir de una muestra del canal auditivo externo 1 y ampliamente distribuido en 5 continentes. En las Américas se reportaron casos múltiples inicialmente en Venezuela 2 y consecutivamente en, Estados Unidos3, Colombia4, Panamá5, Canadá6, y México7. Se ha reportado como responsable de diversos brotes en unidades de cuidados intensivos (UCI) en diversas regiones. Se han identificado varios clados que expresan diferentes perfiles de resistencia antifúngica.
Los pocos estudios realizados en Perú mencionan que las especies del género candida, responsable de candidemia, indican la aparición persistente de especies de candida no albicans como Candida parapsilosis, Candida glabrata y Candida guilliermondii que resultaron resistentes a fluconazol 8. Previo al 2020 Perú no reportó la presencia de Candida auris.
Reportamos los primeros casos de infección por Candida auris en Perú, con la finalidad de fortalecer la vigilancia epidemiológica, el diagnóstico microbiológico y las acciones de prevención y control para su detección y contención oportuna.
REPORTE DE CASOS
Entre agosto y noviembre de 2020, el laboratorio de microbiología del Hospital Nacional Guillermo Almenara Irigoyen EsSalud, aisló 5 cepas sospechosas de Candida auris provenientes de 4 hemocultivos y una de herida, aislados de tres pacientes hospitalizados.
Las muestras de sangre fueron inoculadas en medios de cultivo BD BACTEC Plus Aerobic/F. A partir de los frascos de hemocultivos positivos, se realizó coloración Gram, observándose levaduras con morfología de cándida.
Las cepas obtenidas del agar sangre fueron cultivadas en agar sabouraud-dextrosa y CHROMagarTM Candida (Becton-Dickinson, Francia). Se utilizó como control de calidad las cepas de Candida albicans ATCC 64548 y Candida krusei ATCC 658.
Las cepas aisladas fueron analizadas en el sistema de identificación VITEK(r)2 YST con tarjeta AST - Y08 (BioMèriux, Inc). Los aislamientos obtenidos en agar Sabouraud-dextrosa fueron colonias de color crema, redondas, mucosas, brillantes y de borde liso (Figura 1); y en CHRO- MagarTM Candida se caracterizaron por ser colonias de color violeta pálido, redondas, mucosas y de borde liso (Figura 2).

Figura 1 Todas las cepas en el medio cromogénico CHROMagar Candida mostraron un color rosa claro. Con estos resultados se concluyó que se trataba de Candida no albicans.
Figura 2 Medio CHROMagar Plus se observa en todas las cepas colonias azul claro y halo de color azul, lo que corresponde a diagnostico presuntivo de Candida auris.
El VITEK(r)2 YST identificó a Cándida auris, con un 94% de probabilidad para los aislados. La dificultad para su identificación radica en que la colonia debe de estar aislada perfectamente y el inóculo debe ser alto (2.2 Mc Farland); además, el equipo al discriminar entre las especies de candida, es frecuentemente confundida con Candida famata.
Los aislamientos sospechosos fueron remitidos al Instituto Nacional de Salud (INS) para su confirmación. En total se recibieron 5 cepas correspondientes a los casos 1, 2 y 3. Del caso 1, las cepas N° 1 (hemocultivo) y N° 2 (herida), caso 2, las cepas N° 3 (primer hemocultivo) y N° 4 (segundo hemocultivo) y del caso 3, la cepa N° 5 (hemocultivo).
Los aislamientos fueron sometidos a pruebas rápidas fisiológicas de producción de tubo germinativo y de clamidosporas, que permite diferenciar las especies de Candida albicans de las no albicans 9,10,11. Asimismo, se realizó la prueba de la producción de ureasa. Posteriormente se utilizaron medios cromogénico CHROMagar Candida y el medio CHROMagar Plus.
Los aislamientos fueron confirmados adicionalmente mediante MALDI-TOF MS Biotyper (Bruker Daltonics) MBT versión 4.1.80 en el INS, método considerado como el "gold standard" para la identificación de Candida auris. Se logró identificar aproximadamente 69 picos en cada uno de los 3 aislamientos, los espectros de proteínas obtenidas fueron muy similares entre sí (Figura 3). Las puntuaciones logarítmicas específicas de cada aislamiento (Bruker scores) (Tabla 1) mostraron puntuaciones superiores a 2.0. logrando identificar con éxito los aislamientos como Candida auris.

Figura 3 Espectros de masa de los 3 aislamientos de Candida auris, dentro de un rango de masa de 2000 a 20.000 Da.
Tabla 1 Bruker scores e identificaciónde los tres aislamientos clínicos por espectrometría de masas MALDI-TOF. Puntuaciones superiores a 2.0. para identificación de Candida auris.

A partir de los tres aislados identificados como Candida auris, se seleccionó un aislado correspondiente al caso 1. Este aislado fue sometido a extracción y purificación del ADN genómico el cual fue cuantificado por fluorometría y espectrofotometría. La muestra de ADN fue sometida al ensayo de secuenciamiento genómico utilizando la plataforma MiSeq Illumina (Illumina Inc., USA) utilizando una librería pareada de 300 pb. Las lecturas obtenidas posteriormente fueron ensambladas mediante el programa Geneious Prime v2021.0.3 (Geneious Inc., USA), utilizando como el genoma referencia de C. auris disponible en Genank (BioProject ID PRJNA328792). A partir del análisis de genómica comparativa se confirmó que el aislado de C. auris pertenece al clado IV sudamericano con porcentajes de similaridad de 98-99% con aislados provenientes de Venezuela y Colombia 12.
Se describe sus características clínicas, epidemiológicas y microbiológicas de los tres casos reportados, los cuales se resumen en la tabla 2.
Tabla 2 Características clínicas, epidemiológicas, y susceptibilidad antifúngica, de los tres primeros casos de Candida auris reportados en el Perú.

Caso 1
En la semana epidemiológica 26, ingresó paciente mujer de 47 años con diagnóstico de necrólisis epidérmica tóxica cuya estancia hospitalaria fue de 126 días; estuvo expuesta a catéter venoso central (CVC), catéter urinario permanente (CUP) y ventilación mecánica (VM). A los 21 días, estando en UCI COVID presentó infección de torrente sanguíneo asociado a catéter venoso central (ITS CVC) causada por Pseudomona aeruginosa resistente a carbapenémicos; a los 35 días en la UCI no COVID se aisló la Cándida parapsilosis en hemocultivo; a los 53 días de hospitalización estando en el servicio de dermatología se aisló Candida auris y 4 días después, presentó otra ITS CVC positivo a Acinetobacter baumannii por lo que, nuevamente, recibió tratamiento antibiótico de amplio espectro. La paciente no recibió tratamiento antifúngico, se recuperó y fue dada de alta el día 126. Se realizó la búsqueda de contactos, no encontrándose más casos. Tuvo 2 cultivos de control posteriores los cuales fueron negativos.
Caso 2
En la semana epidemiológica 38, ingresó un paciente varón de 67 años con diagnóstico de infección SARS-CoV 2 con antecedente de hipertensión arterial (HTA) y diabetes mellitus (DM) tipo 2. Al tercer día de hospitalización pasó a UCI COVID-19 estando expuesto a CVC, CUP y VM. A los 11 días de hospitalización se aisló Candida auris en hemocultivo, no recibió tratamiento antifúngico. A los 20 días presentó ITS CVC con hemocultivo positivo a Pseudomona aeruginosa resistente a carbapenémicos, por lo que recibió tratamiento antibiótico de amplio espectro. El paciente falleció a los 21 días de hospitalización por infección SARS-CoV 2.
Caso 3
Varón de 44 años ingresó de emergencia por presentar edema de miembros inferiores y abdomen, oliguria, disnea, diagnóstico de insuficiencia cardiaca congestiva (ICC), Síndrome de Pickwick e infección respiratoria aguda tipo I con antecedente de HTA, DM tipo 2 y obesidad mórbida. Al tercer día de hospitalización pasó a UCI COVID-19, estando expuesto a CVC, CUP y VM. A los 28 días, se aisló Candida auris en hemocultivo y 26 días después presentó ITS CVC con hemocultivo positivo a Pseudomona aeruginosa resistente a carbapenémicos, por lo que recibió tratamiento antibiótico de amplio espectro. No recibió tratamiento antifúngico. El paciente continuó hospitalizado, no presentando contactos.
DISCUSIÓN
Según el CDC-EE.UU., al 13 de enero de 2021, 45 países han reportado casos de Candida auris, de los cuales 14 países presentaron casos únicos, como Chile, Brasil y Costa Rica en Latinoamérica y 31 países casos múltiples como Colombia, México, Panamá y Venezuela en Latinoamérica 13.
La importancia de la detección y reporte de la introducción de la Cándida auris en el Perú se sustenta en que se trata de una levadura emergente asociada a brotes nosocomiales, los pacientes pueden permanecer colonizados con C. auris por tiempos prolongados, su persistencia en algunos tipos de superficies ambientales bajo diferentes condiciones, la poca efectividad de algunos desinfectantes como los amonios cuaternarios, la fácil transmisión entre pacientes, altas tasas de mortalidad en cuadros invasivos y sus diversos perfiles de resistencia antifúngica. Otro aspecto importante de resaltar es la dificultad para su identificación fenotípica requiriendo para su confirmación métodos diagnósticos especializados como el MALDI-TOF o la identificación molecular a través del secuenciamiento 14,15. Todos estos factores facilitan la propagación de este hongo emergente entre pacientes, entre hospitales y entre países, convirtiendo a la C. auris en una seria amenaza a la salud pública mundial.
De los 3 casos aislados en un hospital de alta complejidad de Lima, en dos casos la C. auris se aisló estando hospitalizados en la UCI y un solo caso en el servicio de dermatología. Los 3 casos estuvieron expuestos por lo menos a un dispositivo invasivo, su hospitalización fue prolongada, tuvieron infección bacteriana concomitante y recibieron antibióticos de amplio espectro, un solo caso falleció y ninguno recibió tratamiento antifúngico. Todas las cepas aisladas mostraron resistencia al fluconazol.
En este contexto, el equipo de control de infecciones y de epidemiología del hospital reforzó la vigilancia epidemiológica, la investigación y seguimiento de contactos, las medidas de prevención y control de infecciones, como las precauciones estándar, las precauciones por contacto, el aislamiento hospitalario y reforzaron la limpieza y desinfección de ambientes.
El Ministerio de Salud brindó asistencia técnica para la investigación y control de la introducción de esta cepa emergente. El INS apoyó en la confirmación de la Cándida auris a través de los métodos convencionales, MALDI-TOF y el secuenciamiento genético respectivo. El Centro Nacional de Enlace para el Reglamento Sanitario Internacional realizó la notificación oportuna de la detección de este germen a la Organización Panamericana de la Salud y se emitió la Alerta Epidemiológica N° AE-027-2020 16.
La pandemia de COVID-19 ha determinado el incremento de la demanda de atención en servicios de emergencia, UCI y en servicios de hospitalización, lo que a su vez ha determinado una mayor demanda de profesionales de la salud y un mayor uso de dispositivos invasivos. Este contexto mundial ha determinado la emergencia de microorganismos resistentes, como Cándida auris resistente a fluconazol. El presente reporte y la coyuntura del COVID-19 constituye una oportunidad para fortalecer la vigilancia fúngica en la región, mejorar las prácticas de prevención y control de IAAS, resaltando la detección y diagnóstico oportuno, así como el reforzamiento de las precauciones estándar, el aislamiento hospitalario y la limpieza y desinfección de ambientes.















